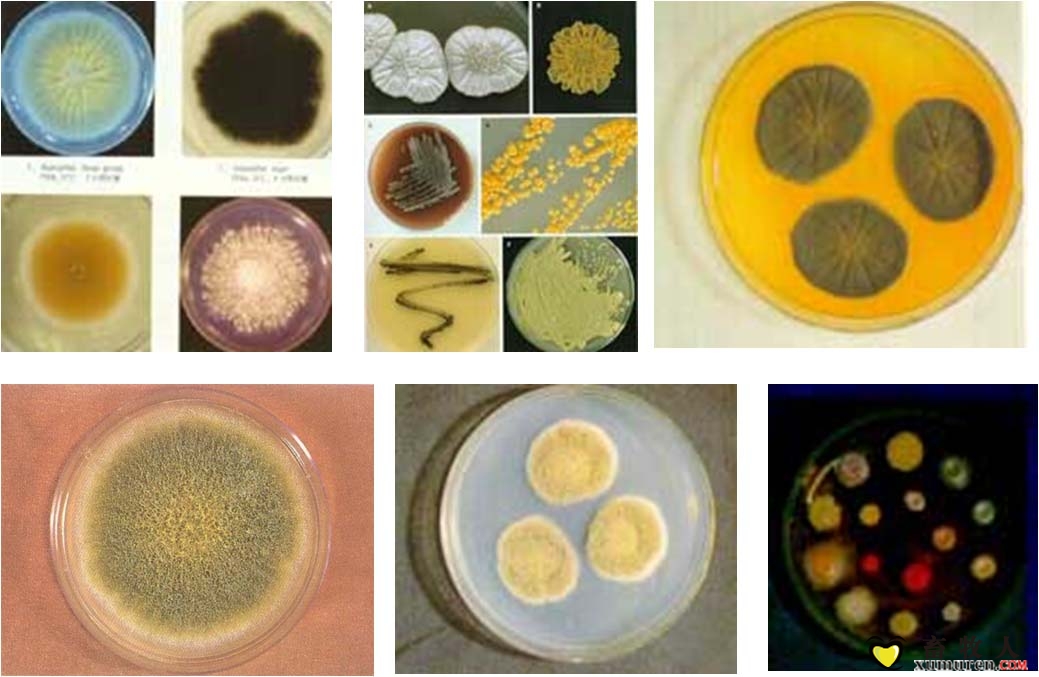

|
發(fā)布時間: 2016-6-24 10:01
正文摘要:文/吳微(愛豬網(wǎng)記者/編輯) 隨著時間的推移,DDGS里的霉菌毒素和玉米籽粒都會對豬只以及家禽的采食量、體重增加、腸道健康、免疫應答和飼料的轉(zhuǎn)化率(FCR)都會產(chǎn)生顯著的影響。這一結(jié)論是由 Alltech提 ... |


畜牧人

畜牧人養(yǎng)豬
關于社區(qū)|廣告合作|聯(lián)系我們|幫助中心|小黑屋|手機版|
 京公網(wǎng)安備 11010802025824號
京公網(wǎng)安備 11010802025824號
北京宏牧偉業(yè)網(wǎng)絡科技有限公司 版權所有(京ICP備11016518號-1)
Powered by Discuz! X3.5 © 2001-2021 Comsenz Inc. GMT+8, 2026-4-19 05:55, 技術支持:溫州諸葛云網(wǎng)絡科技有限公司